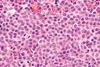
DLBCL

All Advanced therapies manufacturing articles – Page 9
-
 News
NewsCAR T therapy exhibits encouraging proficiency in R/R LBCL
The first study assessing Yescarta® as second-line therapy for transplant ineligible relapsed/refractory (R/R) large B-cell lymphoma (LBCL) demonstrated durable remission rate in a Phase II trial.
-
 News
NewsAdvanced therapy collaboration network launched in Scotland
Advanced therapy (ATMP) manufacturers and developers in Scotland are set to be supported through a new collaboration initiative from the Cell and Gene Therapy Catapult (CGT Catapult).
-
 News
NewsUK ATMP facility granted cGMP approval
A UK CDMO is now permitted through MHRA certification to produce clinical supply of gene therapy AAV, including bioprocess through to cGMP manufacturing.
-
 Article
ArticleHow breakthrough CAR-T cancer therapies could be made more widely accessible
The development and regulatory approval of the first autologous CAR T-cell therapies is a huge advance for modern medicine and has been greeted with justifiable excitement. But applications of this technology are still limited, and given the time and cost constraints, more must be done to broaden access to this ...
-
 News
NewsPioneering PAT to improve gene therapy AAV manufacture
The CGT Catapult and two other collaborators have agreed to work together and use advanced process analytical technologies (PAT) to improve the process and efficiency of gene therapy AAV manufacturing.
-
Whitepaper
Technical document: Introducing: Ami Polymer's Sterile Sampling Systems
Next-Gen Sterile Sampling System: Pinnacle Compliance - USP Standards 87, 88, 85, 661.1, 788, 71, and ISO 11737-1 for Unparalleled Pharma & Biopharma
-
 News
NewsStem cell therapy delivers potential for sickle cell disease
A Novartis’ Phase I/II study for sickle cell disease trialling the gene therapy OTQ92 is the first treatment to target a new genetic area and use cryopreserved stem cells, according to new paper published in NEMJ.
-
 News
NewsCGT manufacturing QC market to value $2.8b by 2031
Advanced analytical technologies in quality control (QC) processes in cell and gene therapy manufacturing is anticipated to help deliver a 24.6 percent market CAGR between 2023 and 2031.
-
 News
NewsRoche subcutaneous cancer immunotherapy granted MHRA approval
The first subcutaneous anti-PD-(L)1 cancer immunotherapy available to patients in Great Britain on the NHS reduces treatment time to under ten minutes.
-
 Whitepaper
WhitepaperReport: Accelerate the RMM validation process
To address the perceived barrier to entry for rapid microbiological methods, new validation packages are now available for Celsis® rapid microbial detection.
-
Video
Webinar: Altasciences’ unique project management offering
Discover Altasciences’ unique project and programme management approach and how it can lower your costs and reduce overall development timelines.
-
 News
NewsUK medicines manufacturing to get innovation boost
A multi-million investment is set to enhance UK medicines manufacturing in three key areas: intracellular drug delivery, digitalisation and automation and nucleic acid medicines.
-
 News
NewsAstellas to advance oncology CAR-T therapy
An investment of $50 million by Astellas Pharma in Poseida Therapeutics’ Phase I allogeneic CAR-T product candidate for solid tumour indications is set to advance the cancer immunotherapy field.
-
 Article
ArticleRegenerative potential: cell‑based therapies for heart failure
Cell-based therapies have the potential to regenerate heart tissue as an alternative to heart transplants. Here, Dr Ibon Garitaonandia, Chief Scientific Officer at CellProthera, shares how CD34+ cells are demonstrating promising results in clinical studies.
-
 News
NewsFinnish manufacturing facility to get €50m expansion
The planned €50 million investment at the Finland-based CDMO facility will enable advanced technologies to be used for development and manufacture of advanced therapy medicinal products (ATMPs).
-
 Whitepaper
Whitepaperebook: Key biomarkers of immunomodulation
Altasciences has published an ebook sharing comprehensive information about testing biomarkers of immunomodulation as part of your drug development program.
-
 Article
ArticleThe evolution of AAVs in cell and gene therapy
AAV development for cell and gene therapy in 2023 is being impacted by manufacturing and regulation challenges, however advancing technologies offer opportunity, according to leaders in the field.
-
 Article
ArticlePreparing for stricter standards on substances of human origin
Manufacturers of innovative therapies and other stakeholders handling blood, tissues and cells must prepare for stronger European rules. Ulf Grundmann, Elisabeth Kohoutek and Lara Sophie Hucklenbroich of King & Spalding elaborate on what this means for manufacturers of advanced therapy medicinal products.
-
Webinar
Determining the right regulatory pathway for your drug
Understanding the different regulatory pathways available is critical to getting your drug to market as quickly and safely as possible.
-
News
NewsBispecific antibody approved in Europe for DLBCL
European approval of the bispecific antibody treatment has the potential to change the current standard of care in diffuse large B-cell lymphoma (DLBCL).



